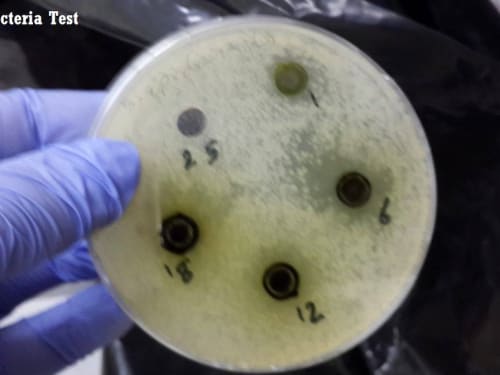

2018
Entries
Dental flossing is very important for preventive healthcare. It costs very little but does require commitment. I invented and patented the Dental Floss Dispenser with Clip, which attaches dental floss to a toothpaste tube. This aids in the commitment part of flossing for good health. This device requires little more than a clip on your dental floss container.
The design of the transmission system for a formula styled racecar using a stock bike engine is one of the best choice for all the engineering students who design the motorsport vehicles for all the student race car build competitions. As there are many rules and restrictions on engine usage such as capacity, maximum power allowed,
Problem Statement:
Generally, Heavy Duty Trucks are used for transportation purpose of cargo with heavy loads and therefore, require a robust steering control (i.e. lateral stability) all the time (especially when moving at a high speed or during cornering) in order to ensure safety of the on-board crew, loaded goods and vehicle itself.
Waven headphones transmit sound through the bones by means of the creation of vibrations, reaching the inner ear, which turn them into electrical impulses. Sound can be perceived by people with normal hearing and also with hearing problems. Moreover, despite playing music, a person can perfectly hear other surrounding sounds.
Through synergies in infrared sensing and drone platforms, we have found a new innovative way to detect hidden PFM-1 anti-personnel landmines. These particular unexploded ordnance (UXO) devices pose a difficult challenge to conventional landmine detection methods like metal detecting, because the mines are primarily composed of plastic and only weigh 75 g.
Biomimetic hands are products which involve a sync between the action of natural fingers with the artificial fingers. In this project they are used in measuring the dimensions of objects for cognition and manipulation possibilities. The methodology involved in this project is the use of NiTi springs (SMA,
Scientists estimate that there are about 10 zillion (10x10^16) fish in the sea, which is more than 1 million fish for every human. About 95% of these fish live deeper than 500 meters under the sea. All of these fish require oxygen to breathe. They do not split water molecules into Hydrogen and Oxygen;
The device shown in the accompanying sketch provides a method of leveling tile by using the device to lift a corner of a tile that is low while simultaneously injecting thin set or adhesive under the tile after it has already been placed.
Healing of wounds for diabetics could be one of the most difficult challenges that diabetes causes. This project aims to help diabetics to heal their wounds using 100% natural herb with low cost. Through using Conyza Canadensis we can extract a variety of chemical compounds that enhance the process of healing and encourage metabolism such as: Flavonoids, Gallic acid,
Page 13 of 57